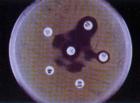
內醯胺酶

作用原理
 內醯胺酶
內醯胺酶β內醯胺類抗生素是一種殺菌劑,它抑制細菌細胞壁中肽聚糖的形成。肽聚糖構成細胞壁、尤其是革蘭陽性菌的細胞壁的主要結構。肽聚糖合成的最後一步是由被稱為青黴素結合蛋白(pennicillin binding proteins,PBPs)的轉肽酶形成的。
β內醯胺類抗生素與D-丙氨醯-D-丙氨酸類似,其終結的胺基酸吸附在正在形成的肽聚糖的前兆NAM-NAG肽單元上。β內醯胺類抗生素與D-丙氨醯-D-丙氨酸結構上的相似使得它們與青黴素結合蛋白結合。β-內醯胺核不可逆地與青黴素結合蛋白的Ser403單元結合。這個不可逆的結合使得青黴素結合蛋白無法連結正在形成的肽聚糖層。此外這個結合可能還激活細胞壁中的自溶酶。
介紹
1.青黴素類抗生素的發展近況
自1940年青黴素投入使用以來,該類抗生素以其療效確切、對人體細胞毒性小且價格低廉而廣泛套用,臨床首選於G+球菌所致的感染。目前,青黴素類抗生素已從抗陽性窄譜品種發展到廣譜的品種,按其抗菌作用可分為:①主要抗G+菌的窄譜青黴素,如天然青黴素G、青黴素V,耐青黴素酶的半合成青黴素甲氧西林、氯唑西林、氟氯西林。②主要作用於G-菌的窄譜青黴素,如美西林、替莫西林。③抗一般G-桿菌的普青黴素,如氨苄西林、阿莫西林、倉氨西林。④抗綠膿桿菌的廣譜青黴素,如羧苄西林、替卡西林、哌拉西林、阿洛西林、阿撲西林等。
已見報導的新型青黴素有替莫西林、福米西林、阿撲西林、阿帕西林等。替莫西林與福米西林分別在青黴烷的C6位上引入了甲氧基與甲醯胺基,因而對β-內醯胺酶穩定。前者對G-菌作用較強,臨床試驗總有效率達93%,不良反應率約2%;後者對腸桿菌屬和綠膿桿菌具有很強的抗菌活性,比青黴素強10~20倍而與亞胺培南相似。阿撲西林引入了第三代頭孢菌素側鏈的2-氨基噻唑肟基,對青黴素結合蛋白PBP2有親和性,抗耐甲氧西林的金葡菌活性較強,組織分布廣,蛋白結合率低,是迄今青黴素中游離濃度最高者,臨床有效率90%,不良反應率1.95%。阿帕西林抗菌譜比氨苄西林和羥苄西林廣且作用強,對青黴素結合蛋白有良好的親和力,細胞穿透力強,並可抑制β-內醯胺酶。它的抗菌譜包括G+菌、沙門菌屬、志賀菌屬、梭狀芽胞桿菌屬、奈瑟菌屬、梭桿菌屬、大腸桿菌、肺炎桿菌、奇異變形桿菌和綠膿桿菌,但對脆弱擬桿菌和耐氨苄西林的流感嗜血桿菌耐藥,半衰期的4.7小時,一般有效率為64%~72%,過敏反應較其它青黴素多見。
內醯胺酶
內醯胺酶隨著青黴素類在臨床的廣泛套用,也不斷顯示出了其不足之處,如抗菌譜窄,抗藥菌株日益增多,穩定性差等,因而有待研製開發出更有效的新型青黴素。
2.頭孢菌素類抗生素的發展近況
頭孢菌素類是50年代開始套用的抗生素,為7-氨基頭孢烷酸(7-ACA)的衍生物。頭孢菌素青黴素的β-內醯胺環張力小,故較青黴素穩定,並且具有抗菌譜廣、殺菌力強和抗青黴素酶的特點,過敏反應少。目前,頭孢菌素類抗生素的頭孢烯類已從第一代發展到第四代,頭霉烯類和氧頭霉烯類已使頭孢菌素從具有抗需氧菌作用發展到具有抗需氧菌和抗厭氧菌的雙重廣譜作用。
2.1第一代頭孢菌素抗菌譜廣,對G+菌作用強,對G-菌作用弱,對β-內醯胺酶不穩定,對綠膿桿菌無效,如頭孢氨苄、頭孢唑啉、頭孢拉定;第二代頭孢菌素抗菌譜較第一代有所擴大,對β-內醯胺酶穩定,但對G+菌的抗菌效能弱於第一代,對G-菌作用較第一代強,對綠膿桿菌無效,如頭孢替安、關孢呋新、頭孢孟多;第三代頭孢菌素對G+菌的抗菌效能普遍低於第一代,對G-菌作用較第二代更強,抗菌譜擴大,對酶的穩定性增強,對綠膿桿菌有效,如頭孢哌酮、頭孢曲松、頭孢唑肟;第四代頭孢菌素與β-內醯胺酶的親和力降低,穩定性提高,對細菌細胞膜的穿透力更強,對甲氧西林敏感的葡萄球菌(MSSA、MSSE)和某些產Ⅰ型β-內醯胺酶的細菌(如陰溝腸桿菌)作用增強,對G-菌的抗菌活性優於第三代頭孢菌素,適用於多重耐藥G-桿菌嚴重感染,對厭氧菌也有很好的抗菌作用,如頭孢地嗪、頭孢噻唑肟、頭孢吡肟等。
鹽酸頭孢吡肟,是呈電中性的兩性離子,具有高度的水溶性,能快速穿透G-菌外膜帶負電的微孔通道,對許多β-內醯胺酶具有低親和力,其作用部位為許多主要的青黴素結合蛋白(PBPs)。其殺菌力強,抗菌譜廣,對G+、G-菌的抗菌活性優於第三代頭孢菌素和亞胺培南。經實驗研究,頭孢吡肟可套用於耐藥機制複雜。治療困難的細菌如弗勞地枸櫞酸桿菌、腸桿菌屬、不動桿菌屬、銅綠假單胞菌所致的感染。}
分類
β-內醯胺酶(β-lactamase)(β酶)的產生是細菌對(β內醯胺類)抗菌藥物耐藥最常見的機制,廣泛地涉及到許多社區獲得性感染和醫院內感染的重要病原菌。β-內醯胺酶的產生是抗生素耐藥的最常見的機制,在各種耐藥機制中占80%。β-內醯胺酶是由多種酶組成的酶家族,能水解β內醯胺抗生素。這些酶的基因存在於細菌的染色體或質粒中。分類比較多而複雜,這裡總結了最常用的兩種,以便大家在閱讀文獻和套用中理清思路。
Bushβ酶分類:根據生化特徵或胺基酸序列的同源性,β-內醯胺酶可分為下列四類。
1第一類為頭孢菌素水解酶(Amp-C酶),產生菌主要系革蘭陰性菌,如假單胞菌、腸桿菌、不動桿菌和克雷伯桿菌等,由染色體介導。
2第二類為青黴素酶和超廣譜酶,包括革蘭陽性菌的青黴素酶,質粒介導的TEM和SHV酶及其衍生物組成的超廣譜β-內醯胺酶(ESBLs)、羧苄青黴素酶、鄰氯青黴素酶(OXA酶)和由沙雷菌屬與腸桿菌屬產生的非金屬碳青黴烯酶。
3第三類為金屬酶,由假單胞菌屬、脆弱擬桿菌屬、產黃菌屬、沙雷菌屬及嗜麥芽黃單胞桿菌屬產生的可水解碳青黴烯抗生素的金屬酶。
4第四類為其他不能被克拉維酸完全抑制的青黴素酶。
Frereβ酶分類(Ambler分類):於β酶的特殊性、動力學參數及其基因的核苷酸序列,將β酶分為A、B、C、D四類
A活性部位為絲氨酸殘基,包括多種質粒編碼的青黴素酶,如TEM1、SHV1、ROB1或PC1酶,相對分子質量29000。
B為金屬酶(metalloenzymes),活性部位為半胱氨酸殘基,產金屬酶的細菌有嗜麥芽黃桿菌(stenotrophomonasmaltophila),氣單胞菌和脆性擬桿菌[7]。該類為碳青黴烯酶,耐藥的抗生素包括碳青黴烯、青黴素、第一、二、三代頭孢菌素、氨曲南.
C活性部位為絲氨酸殘基,相對分子質量為39000,它的產生與β-酶誘導劑有關,歸因於調控基因突變,主要是染色體編碼的頭孢菌素酶(AmpC酶)是由染色體上一組Amp基因介導的。
D為青黴素酶,包括OXA。
有害影響
副作用
β-內醘胺類抗生素的副作用包括:腹瀉、頭暈、疹塊、蕁麻疹、重疊感染(包括念珠菌)(Rossi,2004年)
偶爾β-內醘胺類抗生素還會導致發燒、嘔吐、紅斑、皮膚炎、血管性水腫和偽膜性腸炎(Rossi,2004年)
β-內醘胺類抗生素與β-內醯胺酶抑制劑同時使用時注射處往往會疼痛和發炎。
[
約10%的病人對β-內醘胺類抗生素產生過敏。約0.01%的病人會發生過敏反應(Rossi,2004年)。約5-10%的病人對青黴素衍生物、頭孢菌素和碳青黴烯類抗生素產生交叉敏感。不過不同的學者對這個結論質疑。
雖然如此假如一個病人對一種β-內醘胺類抗生素已經顯示過重過敏反應的話,在給他使用其它β-內醘胺類抗生素時必須慎重考慮。
相關詞條
染色體、OXA、枸櫞酸桿菌、β-酶誘導劑、抗生素

